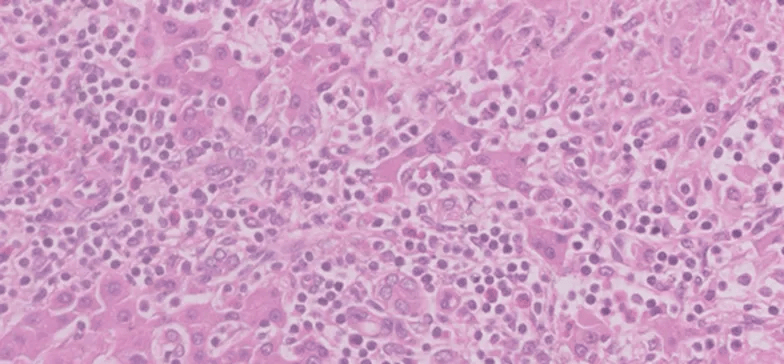
组织学显示非坏死性肉芽肿性病变,由组织细胞,多核巨细胞,淋巴细胞和

虫卵肉芽肿

虫卵肉芽肿
图片尺寸150x102
水光针##水光后异物肉芽肿
图片尺寸690x550
经典病例学习年轻小伙阴囊喷雾头肉芽肿
图片尺寸1134x748
病例分享丨1例被诊断为支气管哮喘十余年的全身型嗜酸性肉芽肿性多
图片尺寸791x496
生育力保存的适应人群肿瘤患者在育龄期及育龄前期,女性常见的恶性
图片尺寸640x243
水光针##水光后异物肉芽肿
图片尺寸690x920
病例分享丨1例被诊断为支气管哮喘十余年的全身型嗜酸性肉芽肿性多
图片尺寸792x496
病例分享丨1例被诊断为支气管哮喘十余年的全身型嗜酸性肉芽肿性多
图片尺寸787x489
8岁男童慢性咳嗽2年ct显示巨大肿块极其容易误诊
图片尺寸1150x976
水光针##水光后异物肉芽肿
图片尺寸690x920
微博新知##全民慢病健康科普计划
图片尺寸640x444
牙龈瘤科普解析|肿块|炎症|肿瘤|乳头_网易新闻
图片尺寸390x266
病例分享丨1例被诊断为支气管哮喘十余年的全身型嗜酸性肉芽肿性多
图片尺寸796x492
病例分享丨1例被诊断为支气管哮喘十余年的全身型嗜酸性肉芽肿性多
图片尺寸795x500
病例分享丨1例被诊断为支气管哮喘十余年的全身型嗜酸性肉芽肿性多
图片尺寸791x493
(1)急性虫卵结节: 为成熟虫卵引起的一种局限性,结节状病变.
图片尺寸569x414
牙龈瘤科普解析|肿块|炎症|肿瘤|乳头_网易新闻
图片尺寸282x266
肉芽肿血管瘤打针基本不会留疤吗
图片尺寸811x1440
水光针##水光后异物肉芽肿
图片尺寸690x920
组织学显示非坏死性肉芽肿性病变,由组织细胞,多核巨细胞,淋巴细胞和
图片尺寸784x364